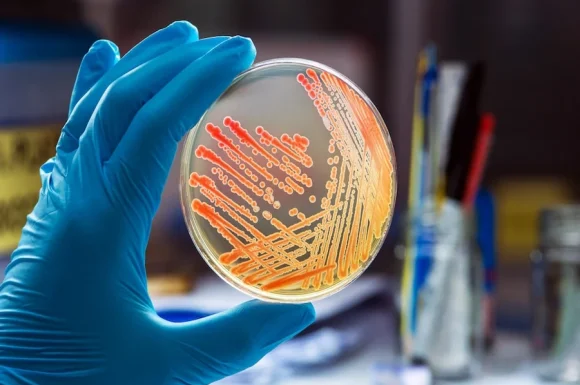

Confira nossas opções de cursos
Duração mínima do curso: 1 ano
Duração mínima do curso: 1 ano
Duração mínima do curso: 360 Horas
Duração mínima do curso: 360 Horas
Duração mínima do curso: 360 Horas
Duração mínima do curso: 4 anos
Duração mínima do curso: 360 Horas
Duração mínima do curso: 40 Horas


O que faz do UniCV a escolha certa?
Com mais de 20 anos de história, o Centro Universitário Cidade Verde (UniCV) é recredenciado com nota máxima pelo MEC, reforçando sua excelência, credibilidade e compromisso com a educação de qualidade.
Já são mais de 160 mil alunos formados e centenas de polos espalhados pelo Brasil e pelo mundo, levando conhecimento e transformação a todos os cantos.
Pós-graduação
Todas as possibilidades para você ir mais longe!
No UniCV, você escolhe como quer estudar: EAD, Semipresencial ou Presencial.
Nosso portfólio oferece graduação em Bacharelado, Licenciatura e Tecnólogo, além das opções de Técnico para Tecnólogo, 2ª Graduação, 2ª Graduação em Licenciatura, Pós-Graduação e Cursos Livres.
São diversas áreas e modalidades pensadas para acompanhar cada etapa da sua carreira, com a credibilidade de uma instituição nota máxima no MEC.

Nota 5
Cursos com nota máxima no MEC

90%
Professores Mestres e Doutores

+160
Cursos de Graduação

+400
Cursos de Pós-Graduação

+390
Cursos de Extensão

+300
Cursos Livres
Confira nossas opções de cursos
Duração mínima do curso: 1 ano
Duração mínima do curso: 1 ano
Duração mínima do curso: 360 Horas
Duração mínima do curso: 360 Horas
Duração mínima do curso: 360 Horas
Duração mínima do curso: 4 anos
Duração mínima do curso: 360 Horas
Duração mínima do curso: 40 Horas
O que nossos alunos estão dizendo?



















Parceria de Sucesso







Últimos Artigos
UniCV firma parceria com a Compass UOL para estágio remunerado em tecnologia
Páscoa Solidária UniCV ultrapassa meta de doações e beneficia 12 instituições
Equipe do UniCV visita Hospital da Criança
UniCV recebe visita internacional para fortalecer programa de internacionalização e inclusão de imigrantes
UniCV fortalece compromisso com a inclusão ao participar do XIII Seminário de Educação Infantil
Curso de Despachante Documentalista EaD do UniCV recebe nota máxima do MEC
Selos de Aprovação